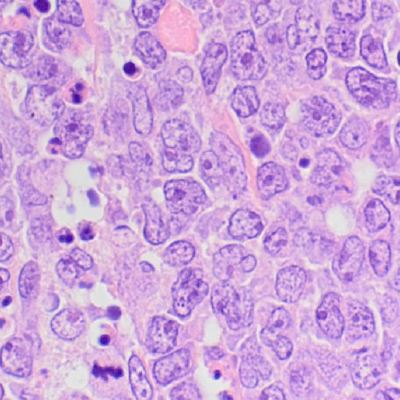
Lymphoma/Leukemia, diagnosis for targeted therapy 2022

Las cookies son unos archivos que se instalan en el equipo desde el que accedes a nuestra web con las finalidades que se describen en esta página.
La aplicación que utilizamos para obtener y analizar la información de la navegación es: Google Analytics
Esta aplicación ha sido desarrollada por Google, que nos presta el servicio de análisis de la audiencia de nuestra página. Esta empresa puede utilizar estos datos para mejorar sus propios servicios y para ofrecer servicios a otras empresas. Puedes conocer esos otros usos desde los enlaces indicados.
Esta herramienta no obtiene datos de los nombres o apellidos de los usuarios ni de la dirección postal desde donde se conectan. La información que obtiene esta relacionada por ejemplo con el número de páginas visitas, el idioma, red social en la que se publican nuestras noticias, la ciudad a la que está asignada la dirección IP desde la que acceden los usuarios, el número de usuarios que nos visitan, la frecuencia y reincidencia de las visitas, el tiempo de visita, el navegador que usan, el operador o tipo de terminal desde el que se realiza la visita.
Esta información la utilizamos para mejorar nuestra página, detectar nuevas necesidades y valorar las mejoras a introducir con la finalidad de prestar un mejor servicio a los usuarios que nos visitan.
Para permitir, conocer, bloquear o eliminar las cookies instaladas en tu equipo puedes hacerlo mediante la configuración de las opciones del navegador instalado en su ordenador.
Cookies are files that are installed on the computer from which you access our website for the purposes described in this page.
The application we use to obtain and analyze the navigation information is: Google Analytics
This application has been developed by Google, which gives us the analysis service of the audience on our page. This company can use this data to improve its own services and to offer services to other companies. You can know these other uses from the links indicated.
This tool does not obtain data of the names or surnames of the users nor of the postal address from where they are connected. The information you get is related, for example, to the number of pages visited, the language, the social network in which our news is published, the city to which the IP address is assigned from which the users access, the number of users that they visit us, the frequency and recidivism of the visits, the time of visit, the browser they use, the operator or type of terminal from which the visit is made.
We use this information to improve our site, detect new needs and evaluate the improvements to be introduced in order to provide a better service to users who visit us.
To allow, know, block or delete the cookies installed on your computer you can do so by configuring browser options installed on your computer.



 LXXXVII Reunión del Club de Linfomas de la Sociedad Española de Anatomía Patológica (SEAP)
LXXXVII Reunión del Club de Linfomas de la Sociedad Española de Anatomía Patológica (SEAP)